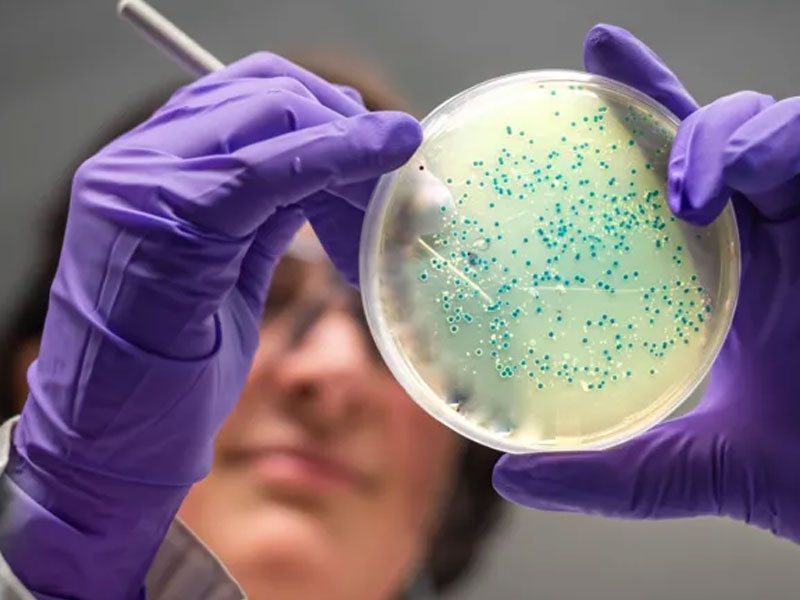

කෘත්රිම බුද්ධිය (AI) මඟින් ගෝනෝරියා සහ MRSA (Methicillin-resistant Staphylococcus aureus) වැනි ප්රතිකාරවලට ඔරොත්තු දෙන බැක්ටීරියා විනාශ කළ හැකි නව ප්රතිජීවක දෙකක් සොයාගෙන ඇති බව පරීක්ෂකයන් අනාවරණය කරගෙන තිබෙනවා.
මැසචුසෙට්ස් තාක්ෂණ ආයතනයේ (MIT) කණ්ඩායමක් විසින් නිර්මාණය කරන ලද මෙම නව ඖෂධ, කෘත්රිම බුද්ධිය විසින් අණුවෙන් අණුවට සැලසුම් කර ඇති අතර, රසායනාගාර සහ සත්ව පරීක්ෂණවලදී එම රෝගකාරක බැක්ටීරියා සාර්ථකව විනාශ කර ඇති බවයි විදෙස් මාධ්ය වාර්තා කරන්නේ.
කෙසේ වෙතත්, මෙම නව සංයෝගයන් සායනික භාවිතය සඳහා නිර්දේශ කිරීමට පෙර තවත් වසර ගණනාවක පර්යේෂණ සහ සායනික අත්හදා බැලීම් අවශ්ය වෙන බවටයි සඳහන් වෙන්නේ.
මෙම සොයාගැනීමත් සමග, MIT කණ්ඩායම පවසන්නේ, ප්රතිජීවක සොයාගැනීමේ ක්රියාවලියට AI තාක්ෂණය යොදා ගැනීමෙන් “දෙවන ස්වර්ණමය යුගයක්” ආරම්භ කළ හැකි බවයි.
ප්රතිජීවක මගින් බැක්ටීරියා විනාශ කළත්, වර්තමානයේ ප්රතිකාරවලට ඔරොත්තු දෙන බැක්ටීරියා නිසා වසරකට මිලියනයකට අධික මරණ සංඛ්යාවක් සිදුවෙනවා.
ප්රතිජීවක අධික ලෙස භාවිත කිරීම නිසා බැක්ටීරියා පරිණාමය වී, ඖෂධවල බලපෑමෙන් ගැලවීමට හැකියාව ලබාගෙන තිබෙනවා.
එමෙන්ම, දශක ගණනාවක් තිස්සේ නව ප්රතිජීවක සොයාගැනීමක් සිදුවී නොමැතිවීමද විශාල ගැටලුවක් වී ඇති බවයි පරීක්ෂකයන් පෙන්වා දෙන්නේ.
මීට පෙර පර්යේෂකයන් කෘත්රිම බුද්ධිය යොදාගත්තේ දැනට පවතින රසායනික සංයෝග දහස් ගණනක් අතරින් නව ප්රතිජීවක සඳහා සුදුසු සංයෝග හඳුනා ගැනීමට පමණයි.
නමුත් මෙම නව සොයාගැනීමත් සමග කෘත්රිම බුද්ධියට මුල සිටම අලුත් සංයෝග නිර්මාණය කිරීමේ හැකියාව ඇති බව පෙන්වා දී තිබෙනවා.